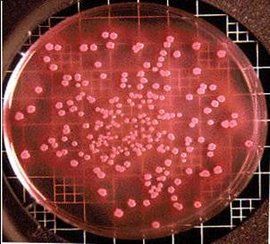
志賀菌 志賀菌

性狀介紹
革蘭染色陰性,桿菌, 無芽胞,無鞭毛,無莢膜,有菌毛.
營養要求不高,在普通瓊脂平板上經過24小時生長,形成直徑達2mm大小、半透明的光滑菌落。志賀菌屬中的宋內志賀菌通常出現扁平的粗糙型菌落。在腸道鑑別培養基上形成無色,半透明的菌落.均能分解葡萄糖只產酸不產氣,除宋內志賀菌遲緩發酵乳糖(一般需3~4天)外,均不發酵乳糖。
引申
抗原構造與分類 有O和K兩種抗原.O抗原是分類的依據,分群特異性抗原和型特異抗原2種,將志賀菌屬分為四群(種)40餘血清型(包括亞型)。從生化特性來看,除A群外,B、C、D群志賀菌菌均能發酵甘露醇(mannitol);除D群外,A、B、C群志賀菌均無鳥苷酸脫羧酶。
志賀菌的抵抗能力比其他腸道桿菌弱,加熱60℃10分鐘就可殺死。對酸和一般消毒劑敏感。在糞便中,由於其他腸道菌產酸或噬菌體的作用常使本菌在數小時內死亡,故糞便標本應迅速送檢。但在污染物品及瓜果、蔬菜上,志賀菌可存活10~20天。適宜溫度下,可在水及食品中繁殖,引起水源或食物型的暴發流行。由於磺胺及抗生素的廣泛運用,志賀菌的多重耐藥性問題日趨嚴重,即使在邊遠地區分離的志賀菌也常見4~8種抗藥譜,極大影響臨床療效。
致病原因
1.致病物質主要是侵襲力和內毒素,有的菌株尚產生外毒素。
(1)侵襲力 借菌毛粘附,穿入迴腸末端和結腸黏膜上皮細胞,在上皮細胞內繁殖,形成感染灶,引起炎症反應.細菌一般不進入血流.志賀菌穿透上皮細胞的能力,由基因所控制.志賀菌只有侵入腸黏膜後才能致病。
(2)內毒素
1)作用於腸黏膜,使通透性增高,促進對內毒素的吸收,引起發熱,神志障礙,甚至中毒性休克等一系列症狀。
2)破壞腸黏膜,形成炎症,潰瘍,呈現典型的膿血粘液便.內毒素還能作用於腸壁植物神經系統,使腸功能發生紊亂,腸蠕動失調和痙攣.尤其是直腸括約肌痙攣最明顯,因而出現腹痛,里急後重等症狀。
(3)外毒素 A群志賀菌I型和II型還能產生外毒素,稱志賀毒素.使蛋白質合成中斷(上皮細胞損傷)。小部分患者志賀毒素可介導腎小球內皮細胞的損傷,導致溶血性尿毒綜合徵(HUS)。
所致疾病
傳染源是病人和帶菌者。
傳播途徑主要為糞一口.人類對志賀氏菌較易感。
痢疾志賀菌引起病情較重;宋內志賀菌多引起輕型感染;福氏志賀菌感染易轉變為慢性,病程遷延;福氏和宋內志賀菌是我國常見的流行型別。
臨床感染類型
(1)急性菌痢 局部症狀有膿血便,腹痛,里急後重。
急性中毒性菌痢,以小兒多見,無明顯的消化道症狀,主要表現全身嚴重的中毒症狀.各型志賀菌都有可能引起.臨床主要有高熱,神志障礙,休克,病死率較高。
(2)慢性菌痢 病程>2月,遷延不愈,局部症狀為主。
3.病後建立的型特異免疫(SIgA)短暫,不持久,無交叉。
免疫性
志賀菌感染恢復後,大多數人在血液中可產生循環抗體,但此種抗體無保護作用。抗感染免疫主要是消化道黏膜表面的分泌型IgA。病後免疫期短暫,也不鞏固,除因細菌感染只停留在腸壁局部外,其類型特別多也是原因之一。
診斷方法
1、螢光菌球檢查法:在含有螢光素標記的志賀菌屬免疫血清的液體培養基中接種標本,培育4-8h,志賀菌屬的細菌,在含相應螢光抗體的培養基中繁殖成帶有螢光的菌球,在低倍或高倍螢光顯微鏡下容易被檢出。
2、協同凝集試驗:使用志賀菌屬抗體標記含有A蛋白的葡萄球菌,測定病人糞便中或增菌培養液中細菌及其可溶性抗原。
3、免疫染色法: 將糞便標本與和志賀桿菌抗血清混勻,在光鏡下觀察有無凝集現象。
4、乳膠凝集試驗:用志賀桿菌抗血清 致敏乳膠,使其與糞便中的志賀菌抗原起凝集反應。
5、分子生物學方法:PCR技術檢測140MD的大質粒等。
防治方法
特異性預防 口服依賴鏈黴素株(Sd)製成的多價活疫苗有一定保護作用。
藥物治療 抗生素,注意多重耐藥菌株。